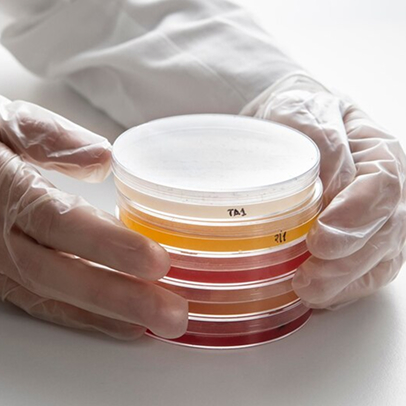
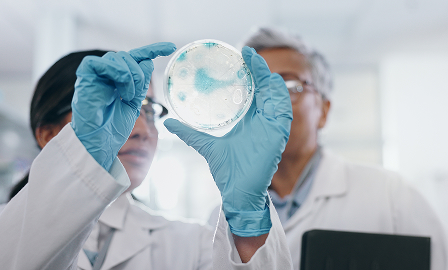
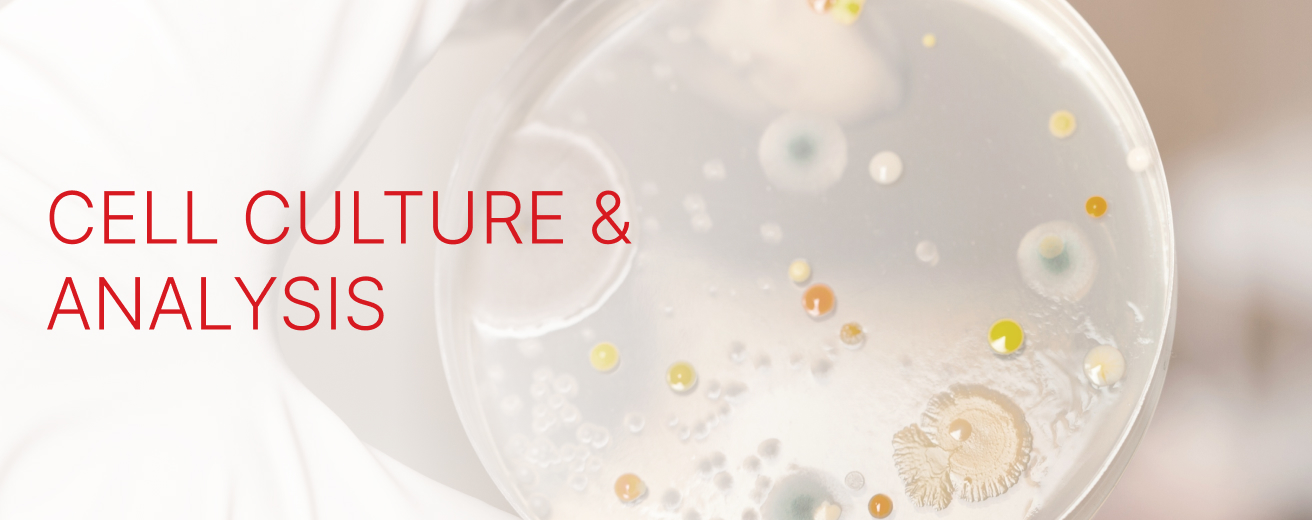
6841da131a8d6.jpg

OVERVIEW
Cell culture and analysis allow scientists to recreate complex biological environments in the lab, offering a controlled window into how cells grow, communicate, and respond to stimuli. This work is essential for exploring disease pathways, testing drug efficacy, and developing novel therapies.
Beyond basic research, cell culture models are critical for reducing reliance on animal testing and improving the predictability of clinical outcomes. As our understanding of cellular ecosystems deepens, these systems are becoming vital tools for translating scientific discovery into meaningful medical breakthroughs.
PROCESS

Cell Growth and Manipulation
Cells are cultured under defined conditions and may be genetically modified or treated to study specific biological responses.

Functional or Phenotypic Analysis
Analyzes cell behavior, protein expression, or drug response using methods like imaging, flow cytometry, or molecular assays.
Reference Standards
Utilizes validated cell lines and controls to ensure consistency and reliability in cell-based analysis, supporting clinical testing.